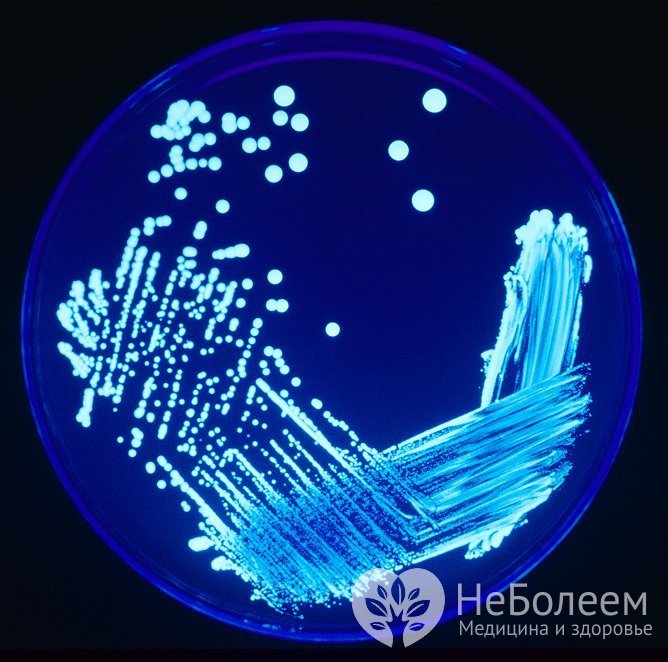
Возбудителем пневмонии могут быть легионеллы

Воспользуйтесь поиском по сайту:
Интерстициальная пневмония: причины, симптомы, лечение
Содержание статьи:
Интерстициальная пневмония (межуточная пневмония, идиопатическая интерстициальная пневмония) представляет собой острое или хроническое воспалительное поражение, затрагивающее стенки альвеол и соединительную ткань паренхимы легких, с возможной внутриальвеолярной экссудацией с последующим переходом в фиброз.
 Для интерстициальной формы пневмонии характерно длительное течение и изменение легочной структуры
Для интерстициальной формы пневмонии характерно длительное течение и изменение легочной структурыДанная форма пневмонии характеризуется длительным тяжелым течением, нередко прогрессирующей фиброзной и склеротической трансформацией легких. Часто заболевание приводит к снижению качества жизни и инвалидизации больных. Обычно встречается у взрослых старше 40 лет. У лиц более молодого возраста или у детей идиопатическая форма пневмонии встречается редко.
Классификация
Основная классификация пневмоний включает следующие формы:
- очаговая;
- очаговая сливная;
- сегментарная;
- долевая;
- интерстициальная.
Интерстициальная пневмония имеет свою классификацию, выделяясь как отдельная группа интерстициальных болезней легких (ИБЛ):
- идиопатический легочный фиброз, или обычная интерстициальная пневмония;
- неспецифическая интерстициальная пневмония;
- криптогенная организующаяся пневмония;
- острая межуточная пневмония, или диффузное альвеолярное повреждение;
- респираторный бронхиолит, ассоциированный с интерстициальными заболеваниями легких (респираторный бронхиолит);
- десквамационная (десквамативная, макрофагальная) интерстициальная пневмония;
- лимфоцитарная (лимфоидная) межуточная пневмония.
Идиопатический легочный фиброз чаще встречается у пожилых мужчин, другие виды более характерны для пациенток женского пола в возрасте 25–55 лет, а неспецифическая и десквамативная форма иногда возникает у детей.
При всех этих формах болезни в той или иной степени развивается дыхательная недостаточность, при которой страдает газообмен.
Причины пневмонии
Причины развития заболевания неизвестны. Выдвигают предположение о причастности нарушения иммунологического гомеостаза, где пусковым фактором служит агент, который, проникнув в организм, приводит к выработке антител.
Возбудителем пневмонии могут быть легионеллы
Возбудителем пневмонии могут быть легионеллыРазвитие интерстициальной формы воспаления легких могут провоцировать инфекции: микоплазмы, хламидии, легионеллы, риккетсии, пневмококки, респираторные вирусы, цитомегаловирус, вирус простого герпеса, а также некоторые виды пыли.
В группу риска входят курящие или ранее курившие лица, ВИЧ-инфицированные и пациенты с аутоиммунными заболеваниями. Имеется связь между коллагенозами и криптогенной организующей пневмонией.
Так, интерстициальное поражение может возникнуть на фоне следующих заболеваний:
- ревматоидный артрит;
- склеродермия;
- полимиозит, или дерматомиозит;
- смешанные болезни соединительной ткани;
- асбестоз;
- хронический гиперчувствительный пневмонит;
- радиационный пневмонит;
- лекарственно-индуцированное поражение легких.
Клиническая картина
Заболевание может иметь гриппоподобное начало: резко появляется лихорадка, непродуктивный кашель и одышка. Сначала одышка отмечается только при физической нагрузке, затем – и в состоянии покоя. Возникают боли в грудной клетке, могут быть эпизоды внезапной нехватки воздуха по ночам. Появляется быстрая утомляемость, общая слабость, плохой сон, снижение аппетита и потеря веса.
 В начале заболевания появляется одышка и кашель
В начале заболевания появляется одышка и кашельСимптомы у большинства пациентов значительно усугубляются в течение 7–14 дней и прогрессируют вплоть до развития дыхательной недостаточности.
При различных формах могут быть разные по выраженности признаки заболевания.
Интерстициальная лимфоцитарная форма имеет незаметное начало с медленным нарастанием кашля, одышки, общей слабости, мышечных и суставных болей. Часто отсутствует лихорадка и выделение кровавой мокроты. С возникновением дыхательных нарушений может развиться кахексия, первичная легочная гипертензия. Легочное сердце при лимфоидной форме может сформироваться за период от 2-х месяцев до 2-х лет.
Синдром Хаммена – Рича, или острое интерстициальное воспаление легких развивается с клиникой гриппа и острого респираторного дистресс-синдрома. Наблюдается молниеносное течение заболевания с быстро прогрессирующей дыхательной недостаточностью и высоким процентом летальных исходов.
Возможные изменения легочной структуры
Интерстициальная форма пневмонии характеризуются различными патологическими изменениями легочной структуры.
 Межуточная пневмония может привести к патологическим изменениям легочной ткани
Межуточная пневмония может привести к патологическим изменениям легочной тканиИзменения легочной структуры в зависимости от формы пневмонии:
|
Форма патологии |
Особенности |
|
Обычная (идиопатическая) форма |
Происходит нарушение архитектуры легких, фиброз с «сотовыми» изменениями. Гистологически определяются фокусы фибробластов, временная гетерогенность фиброзных изменений |
|
Неспецифическая форма |
Характерно вариабельное воспаление интерстиция и фиброз. Изменения становятся однородными, с редкими фибробластическими фокусами в гистологическом материале |
|
Организующаяся форма |
Легочная архитектоника сохранена, в нижних отделах воздухоносных путей наблюдается пятнистое распространение полиповидной грануляционной ткани |
|
Диффузное альвеолярное повреждение легких |
Определяется диффузное утолщение альвеолярных перегородок, организация альвеол, гиалиновые мембраны |
|
Респираторный бронхиолит |
Морфологические изменения включают бронхоцентрическую аккумуляцию альвеолярных макрофагов, минимальное воспаление и фиброз |
|
Десквамационная форма |
Характерно равномерное поражение паренхимы легких, в просвете альвеол определяется большое количество макрофагов, поражение интерстиция минимальное |
|
Лимфоидная форма |
Характеризуется выраженной лимфоцитарной инфильтрацией интерстиция, ассоциированной с перибронхиальными лимфоидными фолликулами |
Читайте также:8 факторов, вредящих здоровью легких
Диагностика
Основные диагностические методы включают:
- клинический анализ крови;
- рентгенологическое исследование органов грудной клетки;
- компьютерная томография высокого разрешения;
- микроскопическое, цитологическое и бактериологическое исследование мокроты;
- гистологическое исследование биоптата легкого.
Заболевание диагностируется врачом при наличии жалоб, симптомов и соответствующей рентгенологической картины.
Во время объективного обследования пациента при аускультации легких выслушивается мягкая крепитация: сначала в прикорневых сегментах легких, затем по всем легочным полям и в верхушках легких.
 Для подтверждения диагноза проводится компьютерная томография легких высокого разрешения
Для подтверждения диагноза проводится компьютерная томография легких высокого разрешенияОтмечается жесткое дыхание, влажные или сухие мелкопузырчатые хрипы в легких. Над областью поражения при перкуссии определяется укорочение звука.
Исследование функции внешнего дыхания путем проведения спирометрии и различных функциональных дыхательных тестов выявляют нарушение вентиляции и расстройства диффузионной способности легких, например, при лимфоидной форме отмечаются изменения рестриктивного типа с резким и крайне резким снижением легочных объемов.
Клинический анализ крови и микробиологические исследования проводятся с целью дифференциальной диагностики с бактериальной пневмоний или туберкулезом, так как специфических изменений при интерстициальной форме пневмонии в большинстве случаев не отмечается.
 Клинический анализ крови имеет важное диагностическое значение
Клинический анализ крови имеет важное диагностическое значениеНа рентгенограмме грудной клетки определяется диффузное двустороннее затемнение легочных полей или прогрессирующие диффузные изменения по типу матового стекла и консолидация. На снимках видно диффузное поражение, определяется утолщение бронхиальной стенки, очаговые или диффузные изменения по типу матового стекла или линейное усиление легочного рисунка. Позже появляются бронхоэктазы (необратимые расширения участков бронха).
При выраженном фиброзе определяется уменьшение объема преимущественно нижних долей легких.
Диагноз подтверждается с помощью компьютерной томографии высокого разрешения, которая помогает оценить распространенность патологического поражения легочной ткани, стадию, активность и темпы прогрессирования фиброзного процесса.
Но в большинстве случаев требуется биопсия, так как данные обследования не всегда специфичны или возможности диагностики нередко ограничены. Именно гистологический анализ является решающим в постановке окончательного диагноза.
Своевременная диагностика положительно влияет на прогнозы.
Лечение
Эффективность лечения зависит от нескольких показателей: степень распространенности поражения легких, наличие сопутствующих заболеваний и осложнений, общее состояние организма человека.
 Важную роль в лечении играет отказ от курения
Важную роль в лечении играет отказ от куренияОбязательным пунктом в лечении является отказ от курения, особенно при десквамативной форме и респираторном бронхиолите.
При большинстве форм фиброзного поражения назначается поддерживающее противовоспалительное лечение, которое включает высокие или средние дозы преднизолона длительным курсом. По показаниям назначаются цитостатики.
При лимфоидной форме назначаются азатиоприн или циклофосфамиды в комбинации с глюкокортикоидным препаратом. Начальная суточная доза преднизолона составляет 1 мг/кг веса. Лечение в среднем проводится в течение 6 месяцев.
В качестве дополнительных антифиброзных средств применяют колхицин, Д-пеницилламин, интерферон гамма-1б. Повышение эффективности терапии отмечается при добавлении к противовоспалительным препаратам N-ацетилцистеина.
При развитии гипоксии необходима оксигенотерапия, при развитии легочной гипертензии – применение вазодилататоров. Развитие инфекций или гнойных осложнений требует назначения антибактериальных и противогрибковых препаратов в зависимости от чувствительности патогенного возбудителя.
Пациенты с интерстициальным поражением легким находятся на постоянном тщательном мониторинге.
 На фоне терапии цитостатиками требуется регулярное проведение исследования мочи
На фоне терапии цитостатиками требуется регулярное проведение исследования мочиПри приеме цитостатиков в течение первого месяца еженедельно необходимо сдавать общий анализ мочи. Затем анализ повторяют один раз в 2–4 недели. При использовании Циклофосфана анализ мочи необходим с целью диагностики гематурии.
Больным с лимфоидной формой пневмонии регулярно проводится вакцинация против гриппа и пневмококковой инфекции.
Осложнения
При своевременной диагностике и начатом в ранние сроки лечении заболевание может прогрессировать медленно, без развития осложнений.
 Одно из возможных осложнений – абсцесс легкого
Одно из возможных осложнений – абсцесс легкогоНо при тяжелом течении, наличии сопутствующей патологии или неадекватной терапии возможны легочные и внелегочные осложнения заболевания:
- плеврит;
- легочная деструкция;
- абсцесс легкого;
- пневмоторакс;
- пиопневмоторакс;
- инфекционно-токсический шок;
- сердечно-сосудистая недостаточность;
- респираторный дистресс-синдром;
- пневмосклероз;
- ДВС-синдром.
Прогноз
Исход пневмонии зависит от распространенности патологического процесса, наличия осложнений, сроков начала терапии и состояния организма. Клиническое улучшение и стабилизация состояния больных на фоне лечения наблюдается в 70% случаев, а в 30% – пациенты имеют десятилетнюю выживаемость.
Большинство случаев лимфоцитарной и криптогенной организующейся пневмонии имеют благоприятный прогноз.
При критическом снижении процессов газообмена и развитии тяжелой дыхательной недостаточности прогноз неблагоприятный. Проводится поддерживающая терапия. При развитии пневмосклероза и сердечно-сосудистой недостаточности продолжительность жизни составляет 3–5 лет.
Видео
Предлагаем к просмотру видеоролик по теме статьи.
Об авторе

Опыт работы: 4 года работы в частной практике.
Нашли ошибку в тексте? Выделите ее и нажмите Ctrl + Enter.
Самая высокая температура тела была зафиксирована у Уилли Джонса (США), который поступил в больницу с температурой 46,5°C.
























